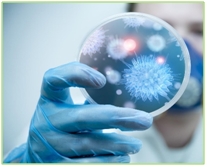
med zaklady

В медичних установах чистота операційної та постільної білизни, а також спецодягу персоналу, являється одним з найважливіших факторів забезпечення протиепідеміологічного режиму та санітарних норм.
В медичних установах чистота операційної та постільної білизни, а також спецодягу персоналу, являється одним з найважливіших факторів забезпечення протиепідеміологічного режиму та санітарних норм.
Брудна білизна – одна з головних потенційних переносників вірусів та бактерій, в наслідок чого виникають так звані «внутрішньолікарняні інфекції», які пацієнти можуть отримати в установах охорони здоров’я, та негативно відобразитись на перебіг лікування паціента. Для запобігання зараження та поширенню інфекційного зараження важливим стає контроль якості прибирання та прання медичної білизни, дезінфекція, та своечасна заміна брудної білизни в лікарнях, будинках пристарілих та хоспісах. Саме тому до технології прання медичної білизни встановлені настільки високі вимоги до якості та дезінфекції прання.

Ми підберемо препарати та розробимо повну технологію обробки всіх типів забруднення, проведемо тестові прання з перевіркою якості, проведемо тренінги персоналу з подальшим тестуванням та підтримкою в режимі 24/7 протягом всього часу співпраці.
Ми маємо всі необхідні знання та препарати, щоб забезпечити максимальну якість прання з урахування специфіки забруднення білизни кожного відділу та потреб на виході:
🧪 Лужні засоби для різного ступеню жорсткості води
🧪Препарати для видалення органічних жиро-масляних забруднень
🧪 Препарати для видалення неорганічних, мінеральних забруднень
🧪 Препарати для видалення білкового забруднення
🧪 Низько та високотемпературні відбілювачі
🧪 Дезінфікуючі препарати
🧪 Препарати фінішної обробки
🧪 Препарати спеціального призначення
🧪 Плямовивідка Christeyns
Процес прання буде повністю автоматизовано, не залежати від людського фактору та відповідати всім санітарним нормам України. Вся продукція тм Christeyns та тм EUROSTARCHEM є висококонцентрована, без фосфатна, має всі необхідні сертифікати в Україні
